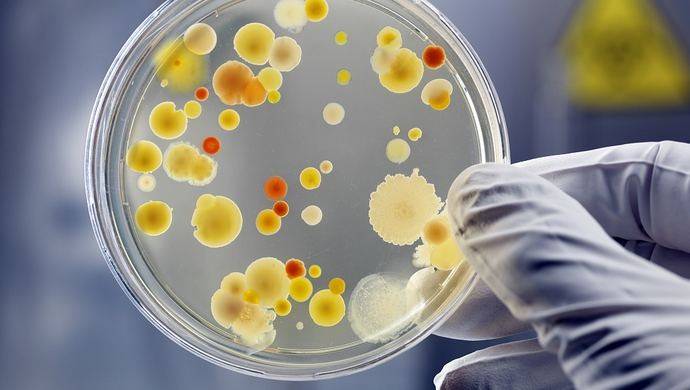

在世界各地的医院中,含有异丙醇或乙醇消毒剂的手洗消毒剂目前正被广泛应用,它确实可以降低名为耐甲氧西林金黄色葡萄球菌(MRSA)的超级细菌的感染率。
但一件可怕的事情正在发生:根据近日发表在《科学》杂志子刊《科学·转化医学》期刊上的一项研究,这种流行的基于酒精的手洗消毒液,现在走在了和抗生素相同的道路上——超级细菌在不断发展中,已经能够抵抗手洗消毒液。
2009年以后,细菌耐受性更强
基于酒精的手洗消毒剂,通常包含了七成以上的异丙醇或乙醇。它们一般能消灭细菌——酒精通过撕开细菌的外膜来杀死它们。因此,这种洗手液以及相关手部清洁方案,在全球范围内都是卫生保健机构控制感染的主要策略,这种方式的引入使得医院中部分获得性感染大幅下降。
然而,原本能轻而易举被杀死的细菌菌株,却逐渐演变出了抵抗能力。
研究人员的调查显示,一种名为屎肠球菌(Enterococcus faecium)的细菌在医院中的感染有上升趋势。
为了更好地了解这种细菌传播的细节,研究团队对1997年至2015年之间在澳大利亚两家医院收集的细菌样本进行了详细分析。结果发现,细菌逐渐能抵抗基于酒精的消毒剂。研究称,与2004年之前收集的细菌样本相比,2009年以后收集的样本对酒精的耐受性更强。
报告指出,2002年医院开始使用含酒精的消毒剂,在收集细菌样本的这两家医院,2001年每月使用100升含酒精的洗手液,但2015年每月使用1000升,用量增加了10倍。
酒精类消毒剂反成“帮凶”?
一方面,细菌逐渐改进了它们对酒精的忍受能力;而另一方面,医院仍在增加使用酒精消毒剂以改善卫生条件和阻止细菌扩散。结合细菌监测数据及小鼠相关实验,研究人员认为,医院采取的酒精消毒措施可能“适得其反”,反而扩大了耐抗生素细菌的传播。
这种肠球菌原本是人类和许多动物中的一种肠道共生菌,但肠球菌的特点就是能生成抵抗药物的物质,使自己不容易被抗生素杀死,而且还容易散播抗药性,几乎已经成为临床感染的重要致病菌。
研究团队的报告显示,目前肠球菌约占全世界医院获得性细菌感染病例的1/10,也是北美和欧洲败血症病例的第四和第五大致病因素。而屎肠球菌又是所有肠球菌感染症中最难治疗的——在澳大利亚的调查发现,屎肠球菌导致了该国1/3的肠球菌感染病例,其中90%都对氨苄青霉素有抗药性,50%对万古霉素也有抗药性。
更棘手的是,现在发现,就算对其使用酒精类消毒剂,细菌的耐药性仍会持续增加。
医院需优化消毒方案
这一新发现意味着,医院原本指望加大酒精类消毒剂的使用以达到阻止细菌传播、降低感染的目的,但是这样做却使得抗药的屎肠球菌提升了其酒精耐受性。
但研究人员也表示,他们还需要更多研究来验证和理解这种“酒精抵抗能力”。
不过,无论造成该细菌抗酒精的原因是什么,它都正在破坏基于酒精消毒剂的标准预防措施的有效性。因此,在某种程度上,这似乎也揭示了为什么欧洲、亚洲以及美洲的医院,都报告了耐万古霉素肠球菌感染的增加。
鉴于此,研究人员呼吁医院重新考量基于酒精的消毒方案,并做出优化。包括足够的用量、充足的消毒时间,以及配合使用或者增加其他清洁制剂与消毒方式。
来源:科技日报